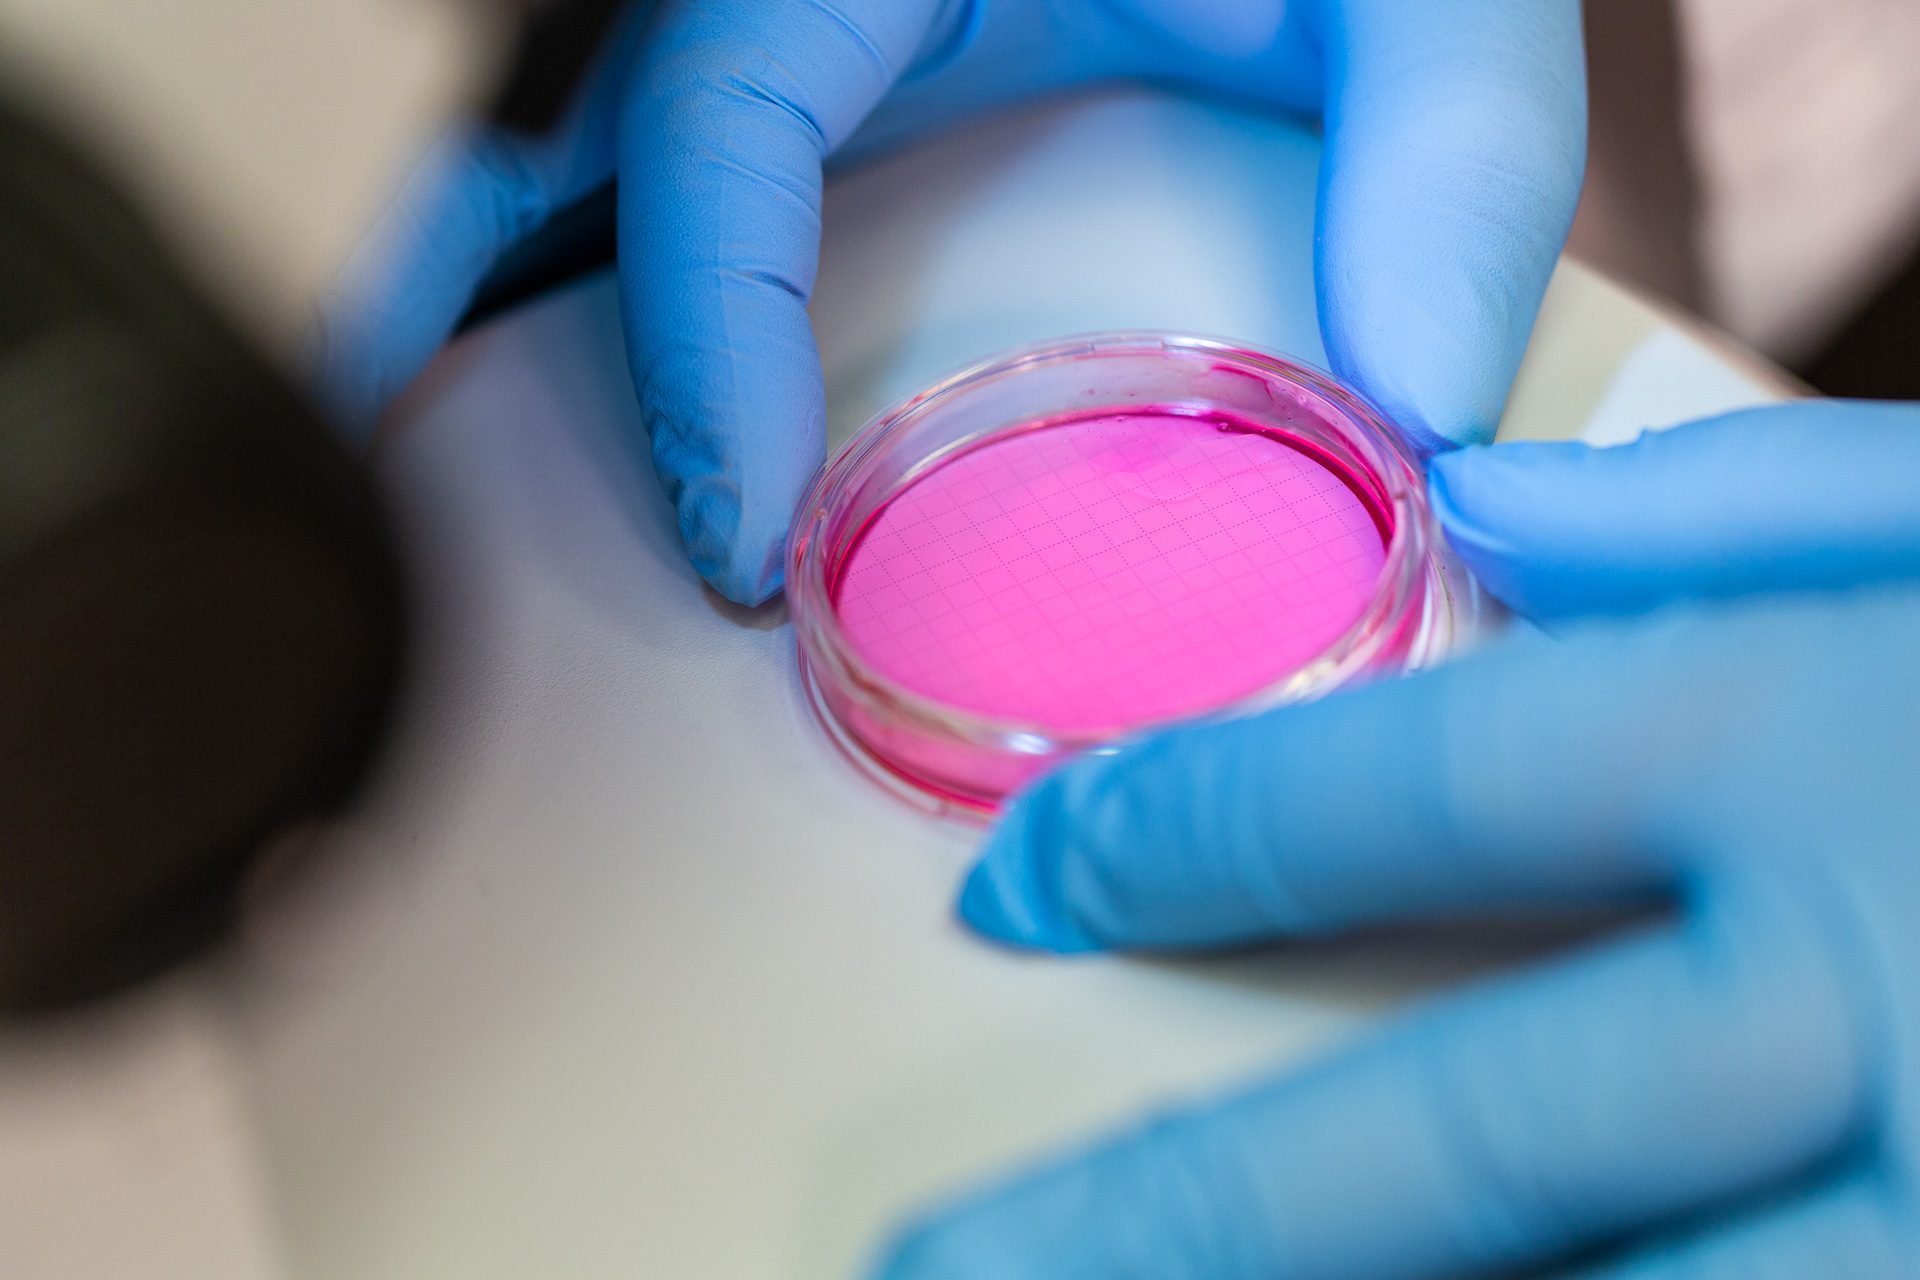

Water Infrastructure Photography – Tampa Bay Water Facility

Tampa Bay Water is a regional utility serving over 2.5 million residents across the Tampa Bay area. This project focused on documenting the scale and complexity of their water treatment infrastructure, capturing both the systems that support distribution and the environments where those systems are monitored and maintained.
Photography was created across multiple facilities, including treatment plants, laboratory spaces, and surrounding infrastructure. Coverage included aerial overviews, process systems, and operational environments to provide a comprehensive visual record of how water moves through each stage of treatment and distribution.
The goal was to build a cohesive image library that supports public communication, internal documentation, and long-term infrastructure planning, while maintaining a consistent visual style across all locations.
By working within active facilities, images were produced in real operating conditions, ensuring accuracy while still maintaining a clean, professional aesthetic suitable for reports, presentations, and marketing materials.
If you’re looking to document water infrastructure, treatment facilities, or large-scale utility operations, feel free to get in touch to discuss your project.
ClientTampa Bay WaterServicesAerial Photography, Industrial PhotographyLinkwww.tampabaywater.org